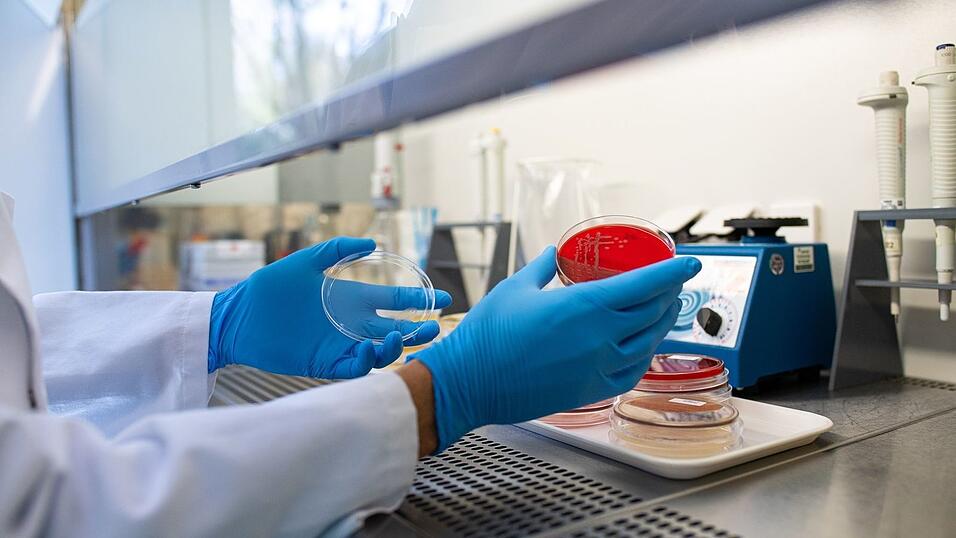

Ausbrüche mit unklarer Ursache
Häufung von Ehec-Infektionen - wie gefährlich ist das?

Manfred Rohde/HZI/HZI/dpa
Die Quelle der aktuellen Infektionen ist in keinem der Fälle bekannt. (Archivbild)
In Mecklenburg-Vorpommern stieg die Zahl erfasster Ehec-Infektionen zuletzt auf 17, betroffen sind vor allem Kinder - mehrere wurden auf Intensivstationen betreut. In belgischen Seniorenheimen erkrankten etwa 20 Menschen an den Bakterien, mindestens vier Menschen starben laut der flämischen Behörde für Pflege und Gesundheit. Die Infektionsquelle ist jeweils noch unklar.
Die Häufung weckt Erinnerungen an einen Ausbruch in Deutschland im Jahr 2011, bei dem rund 3.800 Erkrankungen erfasst wurden und mehr als 50 Menschen starben. Aktuell sieht das Robert Koch-Institut (RKI) keine Hinweise auf eine Häufung von Ehec-Fällen auch in anderen Regionen Deutschlands. Die Situation werde aber weiter sehr genau beobachtet.
Ehec steht für enterohämorrhagische Escherichia coli und bezeichnet bestimmte krankmachende Stämme des Darm-Bakteriums, die vor allem bei Wiederkäuern wie Rindern vorkommen. Die Mikroben können zum Beispiel durch kontaminierte Lebensmittel auf den Menschen übertragen werden.
Sie produzieren sogenannte Shigatoxine: starke Zellgifte, die bei Menschen schwere Durchfallerkrankungen sowie das sogenannte hämolytisch-urämische Syndrom (HUS) verursachen können, eine Komplikation, die zu Nierenversagen führen kann. Kinder sind besonders gefährdet, weil ihr Immunsystem und ihre Organe noch nicht ausgereift sind.
Wie und ob die Ausbrüche in Deutschland und Belgien zusammenhängen, könne man zum jetzigen Zeitpunkt noch nicht sagen, sagt der Vorsitzende der Deutschen Gesellschaft für Pädiatrische Infektiologie, Tobias Tenenbaum. Allgemein seien Kitas und Seniorenheime besonders sensible Bereiche für Durchfallerkrankungen. „Es braucht noch eine gewisse Zeit, um herauszufinden, was die Ursache ist“, so der Kinderarzt. Die Dynamik unterscheide sich aber offensichtlich von Ehec-Fällen im vergangenen Jahr.
Die Suche nach dem Ursprung der Infektionen sei wie Detektivarbeit, erklärt Tenenbaum. In Befragungen müsse herausgefunden werden, ob die Betroffenen ähnliche Orte besucht oder ähnliche Mahlzeiten gegessen hätten. Als besorgniserregend würde er die aktuelle Situation derzeit nicht bezeichnen, man müsse nun aber dringend alle wichtigen Fragen klären
Bisher ist das schwerlich möglich, weil die Quelle der aktuellen Infektionen in keinem der Fälle bekannt ist. Die Behörden in Mecklenburg-Vorpommern prüfen verschiedene mögliche Quellen wie Lebensmittel und Tierkontakte, haben bisher aber kein eindeutig identifizierbares Muster gefunden. In Belgien zeigten Laboranalysen, dass die Infektionen durch denselben Typ des Ehec-Bakteriums verursacht wurden, was auf eine gemeinsame Quelle für diese Infektionen hinweist - welche genau das ist, war zunächst ebenfalls unklar.
Generell sind Hygiene und Vorsicht beim Umgang mit Lebensmitteln angebracht. Rohe tierische Produkte sollten gut durchgegart werden, Obst und Gemüse gründlich gewaschen. Als wahrscheinliche Ursache für den Ausbruch 2011 gelten verunreinigte Sprossen aus Ägypten importierter Bockshornkleesamen.
Vom Verzehr eines verunreinigten Lebensmittels bis zum Ausbruch der Erkrankung dauert es im Durchschnitt drei bis vier Tage, wie es beim Bundesinstitut für Risikobewertung (BfR) heißt. Typisch sind wässriger Durchfall, Übelkeit, Erbrechen und Bauchschmerzen. Bei schwereren Verläufen kann der Durchfall blutig werden und es können Komplikationen wie das HUS mit Nierenversagen folgen. Schon wenige Bakterien reichen aus, um eine Infektion anzustoßen, zudem können Ehec auch direkt von Mensch zu Mensch übertragen werden.
Ehec-Ansteckungen gibt es regelmäßig. Nach Daten des Robert Koch-Instituts zufolge wurden 2023 bundesweit mehr als 3.440 Erkrankungen erfasst, 2024 rund 4.570 und in diesem Jahr bisher etwa 3.660 (Stand 27. August). Im Jahr 2023 waren 5, im Jahr darauf 3 Hus-bedingte Todesfälle gemeldet worden. In Mecklenburg-Vorpommern wurden im Jahr 2024 mehr als 130 Fälle erfasst, im Jahr davor 80. Im aktuellen Fall ist die Aufmerksamkeit dennoch hoch, unter anderem, weil so viele Kinder in recht kurzer Zeit von betroffen sind.